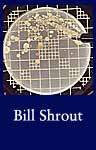

Environmental Studies: Documerica by Photographer
Click on any image to find search results in our online catalog related to that topic.
For the Documerica Project (1971-1977), the Environmental Protection Agency (EPA) hired freelance photographers to capture images relating to environmental problems, EPA activities, and everyday life in the 1970s. The National Archives digitized part of the series "Documerica" (Local ID 412-DA). More than 15,000 of these images are available in the National Archives Catalog.
Are you a teacher? See National Archives' Teaching with Documents lesson plans featuring the following topics:
- Anti-railroad Propaganda Poster -- The Growth of Regionalism, 1800-1860
- Lewis and Clark Expedition
- Migration North to Alaska
- Photographs and Pamphlet About Nuclear Fallout
Additional Resources
- Science & Environment
- National Archives Exhibit: Portrait of Black Chicago (John H. White's Documerica Photographs)
- Project Documerica Web Site (Documerica highlights hosted by the Knight Center for Environmental Journalism at Michigan State University's School of Journalism)